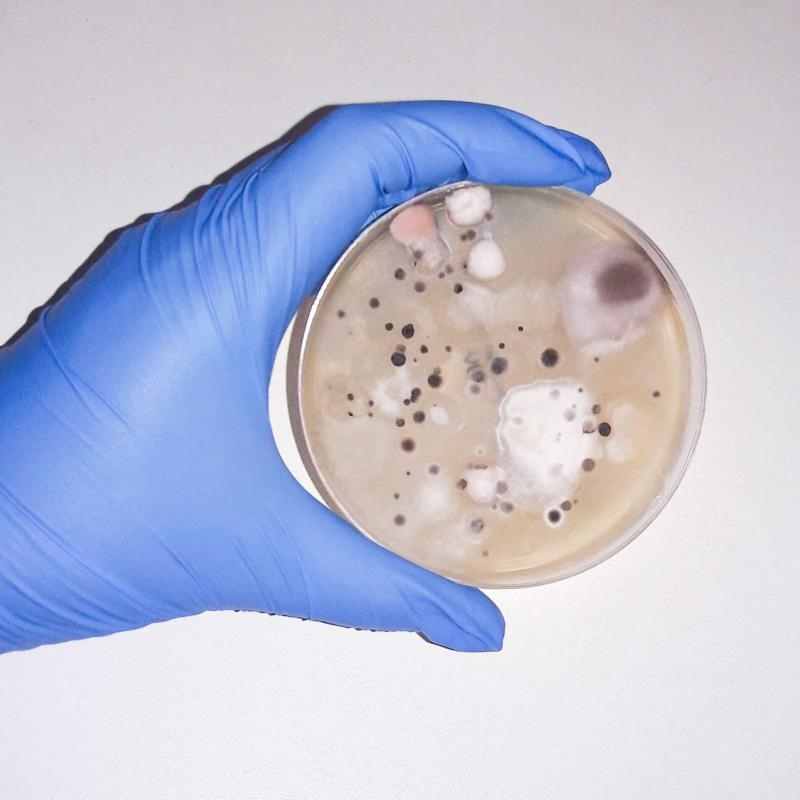

A análises qualidade ar Goiás é obrigatória para todos os ambientes possuem algum tipo de climatização do ar, geralmente realizada por equipamentos específicos e que demandam manutenção periódica. Dentre os principais objetivos da análises qualidade ar Goiás, os de maiores destaques são aqueles que visam verificar a quantidade de dióxido de carbono existente no ambiente, além da presença de fungos patogênicos e toxigênicos extremamente prejudiciais à saúde.
Análise da Qualidade do Ar
Encontrou o que procurava?
Faça seu orçamento grátis agora mesmo!
Regiões onde a atende Análise Solo:
- Abadiânia
- Alto Paraíso
- Alvorada do Norte
- Catalão
- Cavalcante
- Cristalina
- Flôres de Goiás
- Formosa
- Goianésia
- Jaraguá
- Luziânia
- Niquelandia
- Padre Bernardo
- Pirenópolis
- Posse
- Rialma
- São Gabriel.
- São joão d'Aliança
- Terezinha de Goiás
- Uruaçu
- Alto Parnaíba
- Açallândia
- Balsas
- Estreito
- Grajaú
- Imperatriz
- Porto Franco.
- Riachão
- São João do Paraíso
- São Luís
- Tasso Fragoso
- Alagoas
- Bahia
- Distrito Federal
- Goiás
- Maranhão
- Minas Gerais
- Pernambuco
- Piauí
- Tocantins
- Alexânia
- Alvorada
- Araguaçu
- Arraias
- Conceição Do Tocantins.
- Dianópolis
- Gurupi
- Miracema do Tocantins.
- Natividade
- Palmas
- Palmeirópolis
- Paranã
- Peixe
- Pindorama do Tocantins.
- Ponte Alta do Tocantins
- Porangatú
- Porto Nacional
- Santa Rosa do Tocantins.
- Taguatinga
- Araguari
- Arinos
- Buritis
- Chapada Gaúcha
- Januária
- Montes Claros
- Paracatu
- Unaí
- Urucuia
- Arapina.
- Itaparica
- Juazeiro
- Moxotó
- Pajeú
- Petrolina
- Recife
- Salgueiro
- Avelino Lopes
- Corrente
- Curimatá
- Gilbués
- Parnaguá
- São Raimundo Nonato
- Teresina
- Barreiras
- Cocos
- Correntina
- Formosa do Rio Preto
- Luís Eduardo Magalhães
- Riachão das Neves
- São Desidério
- Cabeceira Grande
- Cabeceiras
- Corumbá de Goiás
- Formoso
- Mambaí
- Maceió
- Santa Maria da Vitória
- Santa Rita de Cassia
- Santana
O conteúdo do texto "Análise da Qualidade do Ar" é de direito reservado. Sua reprodução, parcial ou total, mesmo citando nossos links, é proibida sem a autorização do autor. Crime de violação de direito autoral – artigo 184 do Código Penal – Lei 9610/98 - Lei de direitos autorais.